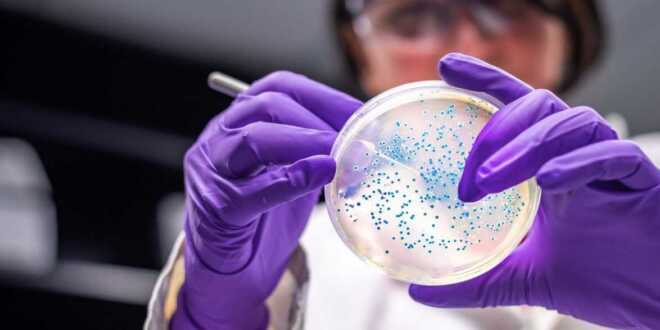

La Klebsiella oxytoca es una bacteria que se encuentra comúnmente en el tracto gastrointestinal de humanos y animales, así como en el medio ambiente. Científicos de la UNAM informaron a la población sobre cómo evitar su propagación.
Agencias
Luego de la alerta epidemiológica declarada el 3 de diciembre por un brote de infección del torrente sanguíneo causado por la bacteria Klebsiella oxytoca en hospitales del Estado de México, y que ha dejado hasta el momento 20 contagios, científicos de la Universidad Autónoma de México (UNAM) explicaron cuáles son los síntomas y cómo evitar su propagación.
El pasado miércoles, la Coordinación de Comunicación Social de la UNAM, organizó una sesión informativa, debido a la alerta epidemiológica que la Secretaría de Salud emitió a través del Sistema Nacional de Vigilancia Epidemiológica (SINAVE) el 3 de diciembre, en el cual informó sobre el “Brote de Infección del Torrente Sanguíneo por Klebsiella oxytoca relacionado a posible contaminación de Nutrición Parenteral (NPT) o insumos relacionados con su aplicación”.
La doctora Rosa María Wong Chew, Jefa de la Subdivisión de Investigación Clínica de la División de Investigación de la Facultad de Medicina de la UNAM, detalló que la bacteria suele encontrarse en el tracto gastrointestinal de humanos, animales o en el medio ambiente y puede causar infecciones graves en personas con sistemas inmunes debilitados.
Panorama en México
Hasta el momento se han identificado 20 casos y se confirmó el fallecimiento de 13 pacientes, los cuales se encuentran en investigación para determinar si la causa de muerte se encuentra relacionada con esta bacteria. Por su parte, siete pacientes continúan bajo atención médica y sus cultivos son negativos, después del tratamiento.
La presidenta Claudia Sheinbaum informó que la Comisión Federal para la Protección contra Riesgos Sanitarios (Cofepris) suspendió el contrato con la empresa que producía soluciones de Nutrición Parenteral (NPT), las cuales, provocaron la muerte de al menos 13 menores en el Estado de México.
En La Mañanera del Pueblo desde Palacio Nacional, la mandataria federal indicó que, desde el primer caso, el secretario de Salud, David Kershenobich atendió a las familias afectadas.
A través de un comunicado, la Secretaría de Salud estatal informó que, en relación con los 13 casos mortales reportados, ocho fueron confirmados por el contagio de la bacteria, mientras cuatro continúan en estudios y uno más está descartado. Los pacientes presentaban comorbilidades y/o enfermedades asociadas propias de su nacimiento.
La Secretaría estatal aseguró que los casos reportados están «bajo control», por lo que hasta el momento no se han registro nuevos casos de contagio.
El dato
Esta cepa es resistente a varios grupos de antibióticos y puede causar infecciones más graves.
FRASE:
“Desde el primer momento el secretario de Salud, es muy triste que haya ocurrido esto, el objetivo es atender a las familias y se está investigando la causa que se dieron en varios hospitales por una bacteria, se suspendió de inmediato el contrato y el registro de este alimento que se da a los pequeñitos, la mayoría son prematuros, Cofepris suspendió la empresa y el secretario de salud está atendiendo».
Claudia Sheinbaum
Presidenta de México
caja
Síntomas
Durante el evento transmitido por YouTube y Facebook Live, la doctora Wong Chew mencionó que las manifestaciones asociadas a este microorganismo son los siguientes:
Infecciones de vías urinarias.
Neumonía, especialmente en personas que tienen alteraciones previas o neumopatías como EPOC o displasia broncopulmonar en los niños.
Infecciones de piel y tejidos blandos, como celulitis, hasta sepsis, es decir, la presencia de la bacteria en el torrente sanguíneo que da una infección generalizada.
Población vulnerable
Personas con sistemas inmunitarios debilitados.
Personas con estancia en cuidados intensivos y hospitales.
Adultos mayores.
Personas con padecimientos pulmonares crónicos.
Y recién nacidos (que en este brote fueron los principales afectados).
Recomendaciones
Como medidas de prevención de la Klebsiella oxytoca, los especialistas hacen las siguientes recomendaciones para evitar muertes y casos más graves:
Notificación inmediata de casos sospechosos: Todo paciente que cumpla con la definición operativa debe ser reportado a las autoridades de vigilancia epidemiológica de manera urgente.
Refuerzo en la higiene hospitalaria: La colocación y manejo de catéteres intravasculares deben realizarse bajo condiciones estériles estrictas, utilizando barreras (guantes, mascarillas, batas y campos estériles), lavado de manos.
Capacitación constante del personal médico: Se deben actualizar las prácticas en prevención de infecciones intrahospitalarias.
Auditorías y supervisión continua: Las unidades médicas deben monitorear de manera activa sus protocolos y los resultados de sus pacientes para identificar y resolver cualquier fallo en las prácticas de atención.
 Novedades de Tabasco El diario mas fuerte de Tabasco
Novedades de Tabasco El diario mas fuerte de Tabasco